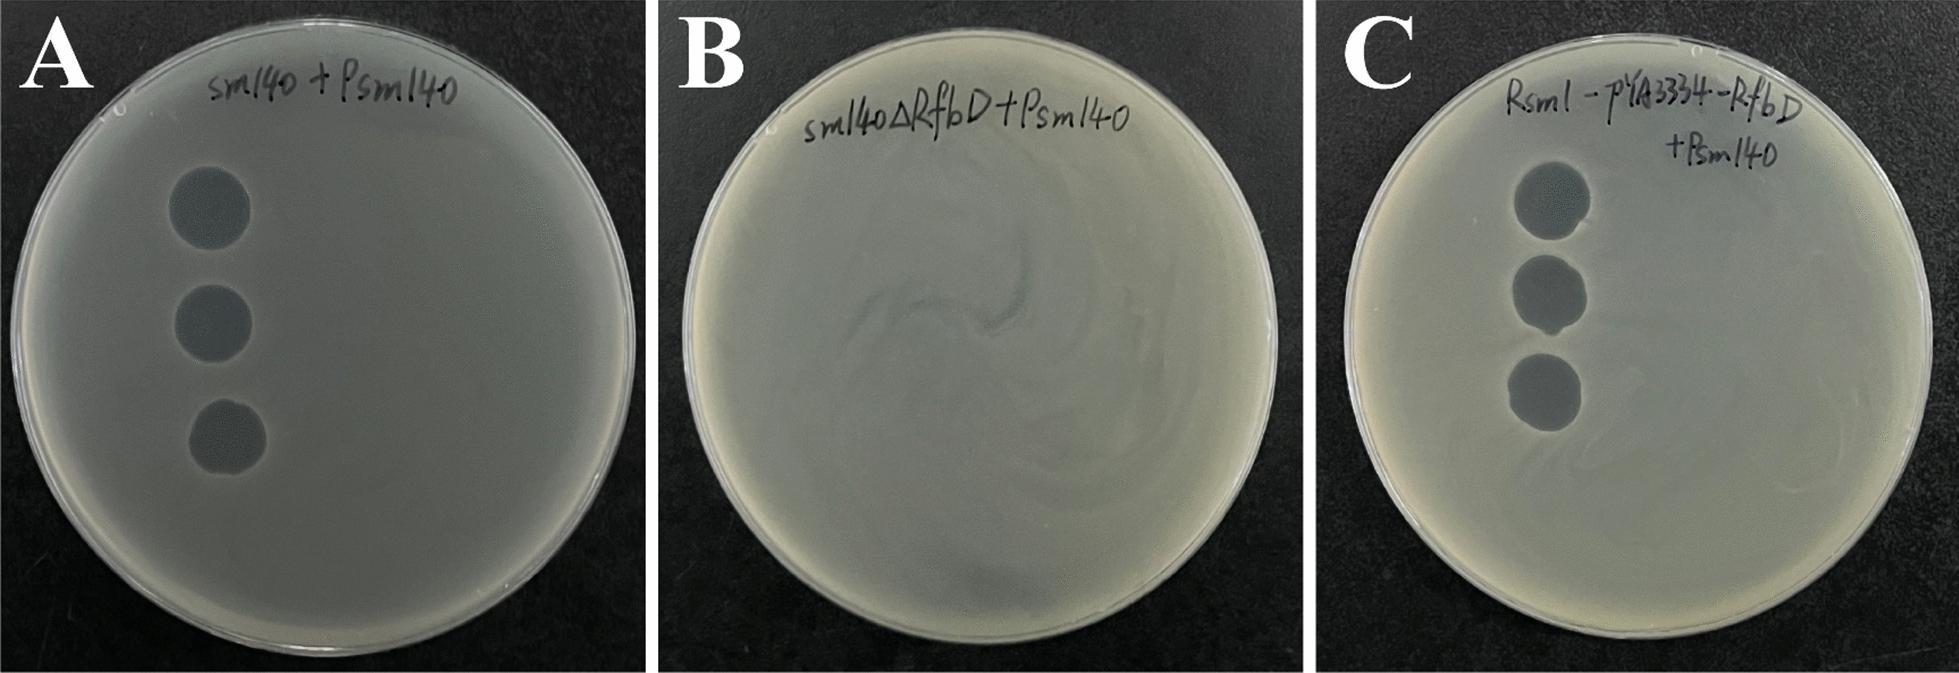

肠炎沙门氏菌通过 rfbD 中的点突变获得噬菌体抗性,但丧失了部分环境适应性。
Salmonella enteritidis acquires phage resistance through a point mutation in rfbD but loses some of its environmental adaptability.
机构信息
College of Veterinary Medicine, Institute of Comparative Medicine, Yangzhou University, Yangzhou, 225009, China.
Jiangsu Co-innovation Center for Prevention and Control of Important Animal Infectious Diseases and Zoonoses, Yangzhou University, Yangzhou, 225009, China.
出版信息
Vet Res. 2024 Jul 5;55(1):85. doi: 10.1186/s13567-024-01341-7.
Phage therapy holds promise as an alternative to antibiotics for combating multidrug-resistant bacteria. However, host bacteria can quickly produce progeny that are resistant to phage infection. In this study, we investigated the mechanisms of bacterial resistance to phage infection. We found that Rsm1, a mutant strain of Salmonella enteritidis (S. enteritidis) sm140, exhibited resistance to phage Psm140, which was originally capable of lysing its host at sm140. Whole genome sequencing analysis revealed a single nucleotide mutation at position 520 (C → T) in the rfbD gene of Rsm1, resulting in broken lipopolysaccharides (LPS), which is caused by the replacement of CAG coding glutamine with a stop codon TAG. The knockout of rfbD in the sm140ΔrfbD strain caused a subsequent loss of sensitivity toward phages. Furthermore, the reintroduction of rfbD in Rsm1 restored phage sensitivity. Moreover, polymerase chain reaction (PCR) amplification of rfbD in 25 resistant strains revealed a high percentage mutation rate of 64% within the rfbD locus. We assessed the fitness of four bacteria strains and found that the acquisition of phage resistance resulted in slower bacterial growth, faster sedimentation velocity, and increased environmental sensitivity (pH, temperature, and antibiotic sensitivity). In short, bacteria mutants lose some of their abilities while gaining resistance to phage infection, which may be a general survival strategy of bacteria against phages. This study is the first to report phage resistance caused by rfbD mutation, providing a new perspective for the research on phage therapy and drug-resistant mechanisms.
噬菌体治疗作为一种对抗多药耐药菌的抗生素替代品具有广阔的前景。然而,宿主细菌可以迅速产生对噬菌体感染具有抗性的后代。在这项研究中,我们研究了细菌对噬菌体感染产生抗性的机制。我们发现,沙门氏菌(Salmonella enteritidis)sm140 的突变株 Rsm1 对噬菌体 Psm140 表现出抗性,而 Psm140 原本能够裂解其宿主 sm140。全基因组测序分析表明,Rsm1 中 rfbD 基因的第 520 位(C→T)发生了单核苷酸突变,导致脂多糖(LPS)断裂,这是由于 CAG 编码谷氨酰胺被终止密码子 TAG 取代所致。sm140ΔrfbD 菌株中 rfbD 的敲除导致其对噬菌体的敏感性随后丧失。此外,在 Rsm1 中重新引入 rfbD 恢复了噬菌体敏感性。此外,对 25 株抗性菌株 rfbD 的聚合酶链反应(PCR)扩增显示,rfbD 基因座的突变率高达 64%。我们评估了四株细菌的适应性,发现获得噬菌体抗性会导致细菌生长速度变慢、沉降速度变快以及对环境的敏感性增加(pH 值、温度和抗生素敏感性)。简而言之,细菌突变体在获得噬菌体抗性的同时丧失了一些能力,这可能是细菌对抗噬菌体的一种普遍生存策略。这项研究首次报道了 rfbD 突变引起的噬菌体抗性,为噬菌体治疗和耐药机制的研究提供了新的视角。